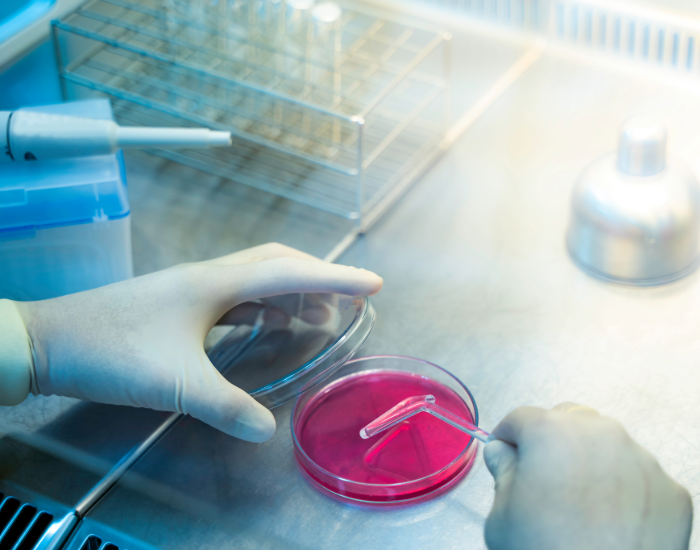
Inoculeren

1. Wat is inoculeren?
Inoculeren is een fundamentele techniek in microbiologie en biotechnologie. Hierbij worden micro-organismen, zoals bacteriën, gisten of schimmels, op een voedingsbodem of in een medium overgebracht om hun groei te bevorderen. Deze techniek is onmisbaar in onderzoek, diagnostiek, productie en kwaliteitscontrole.
Hoe werkt inoculeren?
Het proces begint met het nemen van een monster dat micro-organismen bevat. Met steriele instrumenten, zoals een entoog of pipet, wordt dit monster op een geschikt medium geplaatst. Afhankelijk van het doel kan dit een vloeibaar medium, zoals bouillon, of een vast medium, zoals een agarplaat, zijn. Het inoculeren gebeurt altijd in een steriele omgeving, vaak met behulp van een Bunsenbrander, om contaminatie te voorkomen. Na inoculatie wordt het medium geïncubeerd bij een specifieke temperatuur om de groei van micro-organismen te stimuleren.
2. Toepassingen van inoculatie in verschillende industrieën
Inoculatie is een cruciale techniek die micro-organismen op een voedingsbodem of product overbrengt om groei, productie of analyse te bevorderen. Hieronder enkele belangrijke toepassingen:
- Voedingsmiddelenindustrie: Inoculatie wordt gebruikt bij fermentatieprocessen, zoals de productie van yoghurt, kaas (melkzuurbacteriën), alcohol (gisten) en probiotica.
- Farmaceutische industrie: Essentieel voor het maken van antibiotica, vaccins en biotechnologische producten zoals insuline.
- Landbouw: Bevordert gewasgroei (bijv. stikstofbinding met Rhizobium), compostering en biologische bestrijding van plagen.
- Medisch onderzoek en diagnostiek: Gebruikt bij cultuurtesten, antibioticagevoeligheid en vaccinontwikkeling.
- Milieubiotechnologie: Toegepast in afvalwaterzuivering, bioremediatie en biogasproductie.
- Cosmetica: Voor probiotische huidverzorging en gefermenteerde ingrediënten
- Onderwijs en onderzoek: Studenten en wetenschappers gebruiken inoculatie om micro-organismen te cultiveren en bestuderen.
3. Inoculeren met gereedschappen
Inoculeren gebeurt met diverse gereedschappen, afhankelijk van het type monster en doel. Hier zijn de meest gebruikte hulpmiddelen:
- Entoog of entnaald: Voor het overbrengen van bacteriën op vaste of vloeibare media. Deze worden gesteriliseerd met een Bunsenbrander.
- Drigalski-spatel: Voor gelijkmatig uitstrijken van monsters op een agarplaat. Gesteriliseerd met een autoclaaf of alcoholvlam.
- Pipetten: Handmatig of automatisch gebruikt voor nauwkeurig overbrengen van vloeibare monsters.
- Wattenstaafjes: Voor monsterafname, zoals keel- of huiduitstrijkjes, en direct aan te brengen op media.
- Spuiten en naalden: Gebruikt voor vloeibare media of injecties, vaak eenmalig of gesteriliseerd.
- Autoclaveerbare tandenstokers: Eenvoudig en herbruikbaar voor basisinoculaties.
Lees hier meer over praktisch inoculeren
Steriel werken
Een steriele werkomgeving is essentieel om contaminatie te voorkomen. Gebruik een Bunsenbrander, steriele handschoenen, IPA-spray en labjassen om een steriel veld te creëren. Zorg dat gereedschap en oppervlakken altijd steriel blijven.
5 tips bij inoculeren
- Steriliseer entogen en laat deze afkoelen voordat je ze gebruikt.
- Bewaar agarplaten met het medium naar boven om condensatie te voorkomen.
- Laat het agarmedium op kamertemperatuur komen om temperatuurschokken te vermijden.
- Label petrischalen aan de onderkant, zodat de juiste schaal wordt behouden.
- Behandel agar voorzichtig; het is kwetsbaar als gelatine.

4. Vloeibaar vs. vast medium bemonsteren
Vloeibaar medium
Een vloeibaar medium, zoals bouillon, wordt gebruikt voor massale groei, metabolisch onderzoek en selectieve isolatie.
- Voordelen: Snelle groei, hoge biomassa, eenvoudig mengen.
- Nadelen: Geen afzonderlijke kolonies, gevoeliger voor contaminatie.
- Bemonstering: Gebruik steriele pipetten of spuiten.
Vast medium
Een vast medium, zoals een agarplaat, is ideaal voor kolonie-isolatie, morfologisch onderzoek en kwantificatie.
- Voordelen: Isolatie van kolonies, visuele inspectie, selectieve groei.
- Nadelen: Langzamere groei, minder biomassa.
- Bemonstering: Gebruik een entoog, wattenstaafjes of een Drigalski-spatel.
Vergelijking
- Vloeibaar: Geschikt voor massale groei en snelle cultuurvorming.
- Vast: Ideaal voor isolatie en visuele inspectie.
De keuze hangt af van het doel van de analyse.
5. Hoe kan ik het inoculatieproces versimpelen?
Het traditionele proces van inoculatie kan worden vereenvoudigd met kant-en-klare oplossingen zoals Petrifilm en CompactDry.
- Petrifilm: Een dunne, voorbehandelde film als voedingsbodem.
- CompactDry: Een voorgedroogde voedingsbodem in een compacte houder.
Voordelen:
- Tijdsbesparing: Geen voorbereiding of sterilisatie nodig.
- Minder fouten: Verminderde kans op contaminatie.
- Gebruiksgemak: Alleen een monster toevoegen en incuberen.
- Ruimtebesparend: Compacte vorm, eenvoudig op te slaan.
- Duidelijke resultaten: Kolonies zijn zichtbaar en makkelijk te tellen, soms met kleurindicatoren.
Proces
- Werk steriel.
- Voeg het monster toe (til folie bij Petrifilm of pipetteer op CompactDry).
- Incubeer bij de gewenste temperatuur.
- Lees resultaten af: kolonies worden zichtbaar en telbaar.
Conclusie
Inoculeren is een fundamentele techniek in microbiologie en biotechnologie met brede toepassingen in onderzoek, industrie en diagnostiek. Het proces vereist zorgvuldigheid en steriel werken om betrouwbare resultaten te garanderen. Afhankelijk van het doel kan gebruik worden gemaakt van vloeibare of vaste media, elk met specifieke voordelen.
Innovatieve hulpmiddelen zoals Petrifilm en CompactDry maken het proces efficiënter en gebruiksvriendelijker. Door de juiste technieken, gereedschappen en methoden toe te passen, kan inoculatie optimaal worden ingezet voor uiteenlopende doeleinden, van het kweken van micro-organismen tot kwaliteitscontrole en productie.